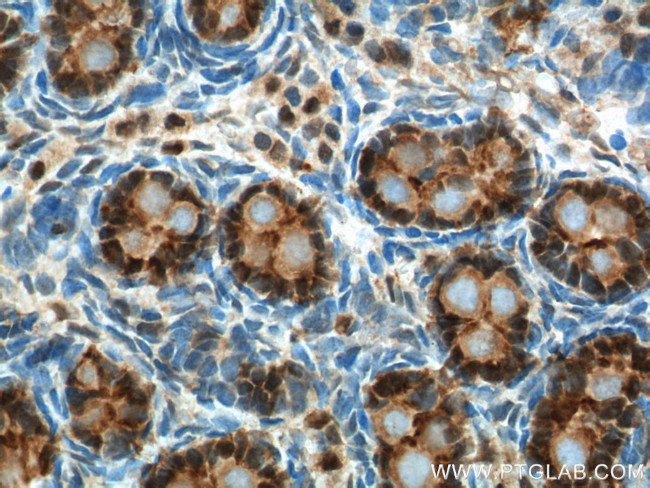
NR5A1 Antibody in Immunohistochemistry (Paraffin) (IHC (P))

Search
Proteintech
NR5A1 Polyclonal Antibody
{{$productOrderCtrl.translations['antibody.pdp.commerceCard.promotion.promotions']}}
{{$productOrderCtrl.translations['antibody.pdp.commerceCard.promotion.viewpromo']}}
{{$productOrderCtrl.translations['antibody.pdp.commerceCard.promotion.promocode']}}: {{promo.promoCode}} {{promo.promoTitle}} {{promo.promoDescription}}. {{$productOrderCtrl.translations['antibody.pdp.commerceCard.promotion.learnmore']}}
产品信息
18658-1-AP
种属反应
宿主/亚型
分类
类型
抗原
偶联物
形式
浓度
规格
纯化类型
保存液
内含物
保存条件
运输条件
产品详细信息
Immunogen sequence: MDYSYDEDL DELCPVCGDK VSGYHYGLLT CESCKGFFKR TVQNNKHYTC TESQSCKIDK TQRKRCPFCR FQKCLTVGMR LEAVRADRMR GGRNKFGPMY KRDRALKQQK KAQIRANGFK LETGPPMGVP PPPPPAPDYV LPPSLHGPEP KGLAAGPPAG PLGDFGAPAL PMAVPGAHGP LAGYLYPAFP GRAIKSEYPE PYASPPQPGL PYGYPEPFSG GPNVPELILQ LLQLEPDEDQ VRARILGCLQ EPTKSRPDQP AAFGLLCRMA DQTFISIVDW ARRCMVFKEL EVADQMTLLQ NCWSELLVFD HIYRQVQHGK EGSILLVTGQ EVELTTVATQ AGSLLHSLVL (1-349 aa encoded by BC032501)
靶标信息
Steroidogenic factor-1 (SF-1) is an orphan nuclear receptor involved in organ development and differentiation of the endocrine system. SF-1 has been shown to be essential for fetal development of the hypothalamus, pituitary gland, gonads, and the adrenal gland. SF-1 has been shown to promote transcriptional activity of many steroidogenic enzymes from the cytochrome P450 family. SF-1 contains two activation function domains, designated AF1 and AF2, common to many nuclear steroid receptors which have been shown to be necessary for interaction with other nuclear receptors as well as coactivators and corepressors including steroid receptor coactivator-1 (SRC-1), glucocorticoid receptor interacting protein 1 (GRIP1), cAMP response element binding protein (CREB) binding protein (CBP) and silencing mediator of retinoid acid and thyroid hormone receptor (SMRT).
仅用于科研。不用于诊断过程。未经明确授权不得转售。
生物信息学
蛋白别名: adrenal 4 binding protein; Adrenal 4 binding protein (AD4BP); Adrenal 4-binding protein; ELP; Embryonal long terminal repeat-binding protein; Embryonal LTR-binding protein; fushi tarazu 1 factor homolog; Fushi tarazu factor homolog 1; Fushi tarazu factor homolog 1 (FTZ1); nuclear receptor AdBP4; Nuclear receptor subfamily 5 group A member 1; Nuclear receptor subfamily 5 group A member 1 (NR5A1); putative new variant; SF-1; Steroid hormone receptor Ad4BP; Steroid hydroxylase positive regulator; Steroidogenic factor 1; Steroidogenic factor 1 (SF1); steroidogenic factor 1 nuclear receptor; steroidogenic factor-1; STF-1; STF1
基因别名: AD4BP; Ad4BP/SF-1; ELP; ELP-3; Ftz-F1; FTZ1; FTZF1; hSF-1; NR5A1; POF7; SF-1; SF1; SPGF8; SRXX4; SRXY3
UniProt ID: (Human) Q13285, (Mouse) P33242, (Rat) P50569
Entrez Gene ID: (Human) 2516, (Mouse) 26423, (Rat) 83826